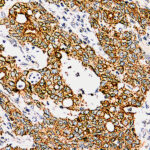

|
|---|
 Anti-Cytokeratin, High MW Anti-Cytokeratin, High MWBuy here |
 Anti-Cytokeratin, Low MW Anti-Cytokeratin, Low MWBuy here |
 Anti-Cytokeratin, Pan Anti-Cytokeratin, PanBuy here |
 Anti-Cytokeratin, Pan Anti-Cytokeratin, PanBuy here |
 Anti-Cytomegalovirus (CMV) Anti-Cytomegalovirus (CMV)Buy here |
 Anti-Cytomegalovirus (CMV) Anti-Cytomegalovirus (CMV)Buy here |
 Anti-Desmin Anti-DesminBuy here |
 Anti-Desmoglein 1 Anti-Desmoglein 1Buy here |
 Anti-Desmoglein-3, Clone DSG3/2839 Anti-Desmoglein-3, Clone DSG3/2839Buy here |
 Anti-DOG1 Anti-DOG1Buy here |